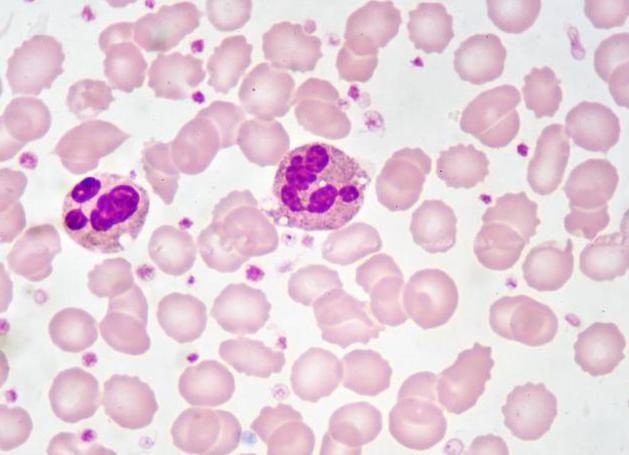

血常规是一种常见的临床检查办法,它能够经过检测血液中的各项指标来评价人体的安康情况。
血常规包括白细胞计数、红细胞计数、血红蛋白、血小板计数等多个指标,这些指标能够反映出人体的免疫功用、贫血水平、出血倾向等多个方面的状况。
在临床应用中,血常规能够用于诊断和监测多种疾病,同时,血常规也能够用于评价人体的安康情况,及时发现潜在的安康问题,从而采取相应的预防和治疗措施。
值得留意的是,血常规固然是一种常见的检查办法,但是其结果并不能完整代表人体的安康情况。

因而,在停止血常规检查时,一定要分离其他检查结果和临床表现停止综合剖析,以确保诊断结果的精确性和牢靠性。
01血常规检查能够查出哪些疾病?
首先,血常规检查能够检测贫血。贫血是指血液中红细胞数量或质量缺乏,招致氧气无法充沛保送到身体各个部位,从而惹起疲倦、乏力等病症。
血常规检查能够丈量血红蛋白、红细胞计数、红细胞压积等指标,从而判别能否存在贫血。
其次,血常规检查还能够检测感染和炎症。感染和炎症会招致白细胞数量增加,因而血常规检查能够丈量白细胞计数、中性粒细胞计数等指标,从而判别能否存在感染和炎症。

此外,血常规检查还能够丈量C反响蛋白等指标,进一步判别炎症的水平和病情的严重水平。
02血常规检查中,假如3个指标升高,要惹起警觉,别大意了
血常规检查是常见的体检项目,经过检测血液中的各项指标来评价身体的安康情况。在这些指标中,有三个指标升高可能意味着身体呈现了一些问题,需求惹起警觉。
这三个指标分别是白细胞计数、红细胞计数和血小板计数,白细胞计数是指血液中白细胞的数量,白细胞是身体的免疫细胞,它们能够对立病毒、细菌和其他外来物质。
假如白细胞计数升高,可能意味着身体正在应对某种感染或炎症,或者存在某种免疫系统疾病。
红细胞计数是指血液中红细胞的数量,红细胞是携带氧气到身体各个部位的细胞。假如红细胞计数升高,可能意味着身体正在应对某种贫血或其他心血管系统疾病。
血小板计数是指血液中血小板的数量,血小板是身体止血的关键细胞。假如血小板计数升高,可能意味着身体正在应对某种出血或凝血障碍疾病。
因而,当我们停止血常规检查时,假如发现这三个指标中有一个或多个升高,我们应该惹起警觉,及时就医并承受进一步的检查和治疗。
03血常规能不能检查出癌症?
关于癌症的检测来说,血常规并不是最为精确和牢靠的办法。固然血常规能够检测出一些癌症相关的指标,比方白细胞计数、红细胞计数、血小板计数等,但这些指标并不能直接阐明患者能否患有癌症。

由于这些指标的变化可能是由其他疾病或生理状态惹起的,所以需求分离其他检查办法和临床表现来综合判别。
关于癌症的检测,目前比拟常用的办法是肿瘤标志物检测、影像学检查和组织学检查。肿瘤标志物检测能够经过检测血液中的某些特定蛋白质或物质来判别能否存在癌症细胞的存在,但这种办法也存在一定的误诊率和漏诊率。
影像学检查能够经过X光、CT、MRI等技术来察看人体内部的状况,但也存在一定的局限性。组织学检查则是经过获得组织样本停止病理学检查,能够明白诊断能否为癌症。
04血常规检查有哪些留意事项?
首先,患者在停止血常规检查前需求空腹。普通来说,患者需求在检查前8-12小时内禁食,只能饮水。这是由于进食会影响血液成分的测定,招致检查结果不精确。

其次,患者在停止血常规检查前需求中止服用某些药物。一些药物会影响血液成分的测定,因而在停止血常规检查前需求中止这些药物的运用。详细需求中止哪些药物,患者需求咨询医生或检查医师的倡议。
另外,患者在停止血常规检查前需求坚持充足的休息和睡眠。过度疲倦、缺乏睡眠会影响血液成分的测定,招致检查结果不精确。
最后,患者在停止血常规检查前需求坚持心情高兴,防止心情动摇。心情动摇会影响血液成分的测定,招致检查结果不精确。